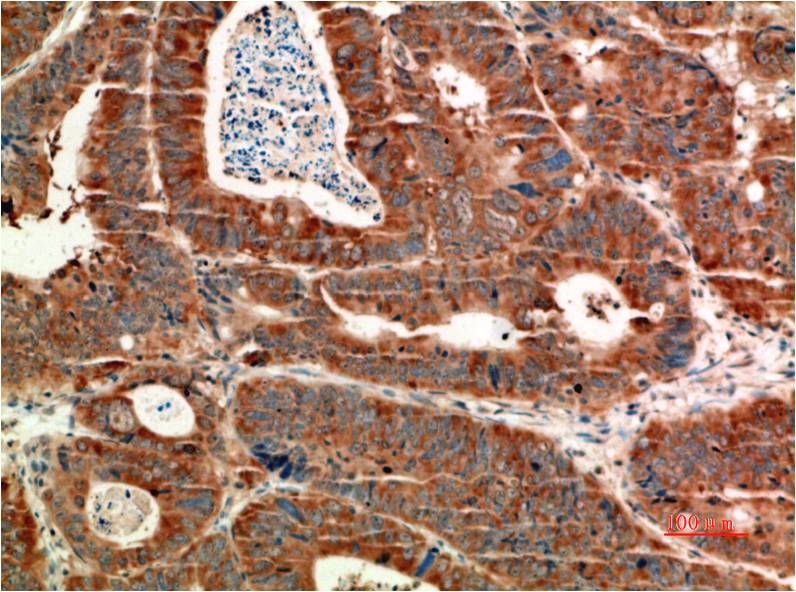

ATM Mouse Monoclonal Antibody(4C8)
Catalog NO.:BE3667
Applications :IHC
Reactivity :H, R, M
| 货号 | 规格 | 品牌 | 库存 | 价格 | 数量 | 操作 |
|---|---|---|---|---|---|---|
| BE3667-100 | 100ul | EASYBIO |
|

Ataxia telangiectasia mutated kinase (ATM) is a serine/threonine kinase that regulates cell cycle checkpoints and DNA repair. ATM kinase regulates a number of proteins involved in cell cycle checkpoint control, apoptosis, and DNA repair.
| Product Name: | ATM Mouse Monoclonal Antibody(4C8) |
|---|---|
| Isotype: | IgG1 |
| Storage Buffer : | PBS, pH 7.4, containing 0.02% sodium azide as Preservative and 50% Glycerol |
| Storage instructions: | -20°C. Do not aliquot the antibody |
| Recommended dilutions: | IHC: 1:100-200 |
| Optimal dilutions should be determined by the end user. | |
| Specificity: | The ATM Mouse Monoclonal Antibody can detects endogenous ATM proteins. |
| Alternative Names: | AT1,ATA,ATDC,TEL1,A-T mutated antibody |
| Form: | Liquid |
| Reactivity: | H, R, M |
 暂无参考文献!
暂无参考文献!